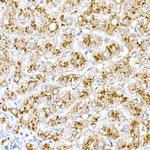
Cathepsin D Antibody in Immunohistochemistry (Paraffin) (IHC (P))

Search
Invitrogen
Cathepsin D Polyclonal Antibody
{{$productOrderCtrl.translations['antibody.pdp.commerceCard.promotion.promotions']}}
{{$productOrderCtrl.translations['antibody.pdp.commerceCard.promotion.viewpromo']}}
{{$productOrderCtrl.translations['antibody.pdp.commerceCard.promotion.promocode']}}: {{promo.promoCode}} {{promo.promoTitle}} {{promo.promoDescription}}. {{$productOrderCtrl.translations['antibody.pdp.commerceCard.promotion.learnmore']}}
图: 1 / 4
Cathepsin D Antibody (PA5-89138) in IHC (P)

Please note: We are reviewing Western blot images included in the antibody testing data in our catalog, including those provided by third parties. Unless expressly labeled or annotated as “raw-unedited”, Western blot images included in the antibody testing data in our catalog may have been edited, optimized or otherwise adjusted for presentation.
产品信息
PA5-89138
种属反应
宿主/亚型
分类
类型
抗原
偶联物
形式
浓度
规格
纯化类型
保存液
内含物
保存条件
运输条件
RRID
产品详细信息
Immunogen sequence: LVRIPLHKFT SIRRTMSEVG GSVEDLIAKG PVSKYSQAVP AVTEGPIPEV LKNYMDAQYY GEIGIGTPPQ CFTVVFDTGS SNLWVPSIHC KLLDIACWIH HKYNSDKSST YVKNGTSFDI HYGSGSLSGY LSQDTVSVPC QSASSASALG GVKVERQVFG EATKQPGITF IAAKFDGILG MAYPRISVNN VLPVFDNLMQ QKLVDQNIFS FYLSRDPDAQ PGGELMLGG
Positive Samples: Mouse kidney, Mouse heart; Cellular Location: Lysosome, Melanosome, extracellular space
靶标信息
Cathepsin D is a gene located on chromosome 11p15.5 that encodes a lysosomal aspartic protease involved in the degradation of proteins. This enzyme is widely expressed in various tissues but is particularly abundant in the liver, kidneys, and brain, where it plays a crucial role in intracellular protein catabolism and turnover. Cathepsin D is synthesized as an inactive precursor, procathepsin D, which is activated in the acidic environment of lysosomes. Beyond its fundamental role in protein degradation, Cathepsin D has been implicated in several physiological and pathological processes, including apoptosis, hormone processing, and antigen presentation. Dysregulation of Cathepsin D expression or activity is associated with various diseases, such as neurodegenerative disorders, cancer, and cardiovascular diseases. In the context of cancer, Cathepsin D overexpression has been linked to tumor progression and metastasis, making it a potential biomarker and therapeutic target. Research continues to explore its diverse biological functions and therapeutic implications in various medical conditions.
仅用于科研。不用于诊断过程。未经明确授权不得转售。
篇参考文献 (0)
生物信息学
蛋白别名: Cathepsin D; CathepsinD; Ceroid lipofuscinosis neuronal 10; ceroid-lipofuscinosis, neuronal 10; CTSD; epididymis secretory sperm binding protein Li 130P; lysosomal aspartyl peptidase; lysosomal aspartyl protease; MGC2311; OTTHUMP00000196039; OTTHUMP00000198692; preprocathepsin D
基因别名: CatD; CD; CLN10; CPSD; CTSD; HEL-S-130P
UniProt ID: (Mouse) P18242
Entrez Gene ID: (Human) 1509, (Mouse) 13033, (Rat) 171293




